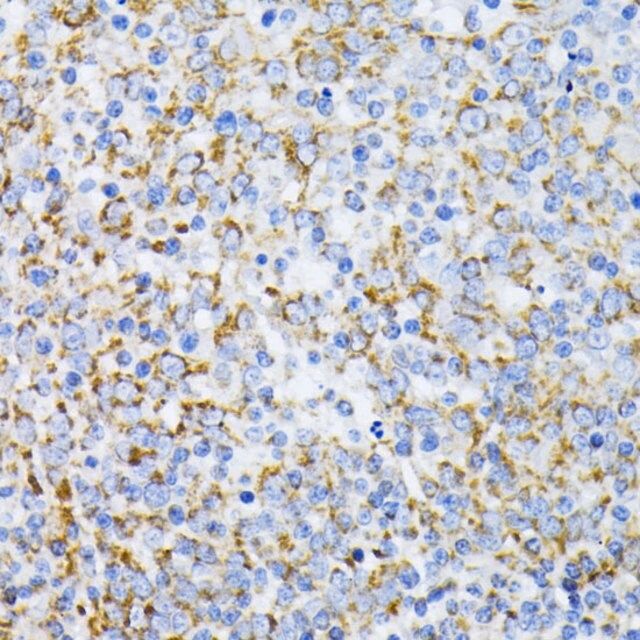

您的位置:首页 > 产品中心 > Anti-Cytochrome c antibody produced in rabbit
Anti-Cytochrome c antibody produced in rabbit

产品别名
Anti-Cytochrome c antibody produced in rabbit
CYC
HCS
THC4
Cytochrome c
CYCS
产品性质
| biological source【生物来源】 | rabbit |
| Quality Level【质量水平】 | 100 |
| antibody form【抗体形式】 | affinity isolated antibody |
| antibody product type | primary antibodies |
| clone【克隆】 | polyclonal |
| form【形式】 | buffered aqueous solution |
| mol wt【分子量】 | 11 |
| species reactivity | human, mouse, rat |
| concentration【浓度】 | 0.73 mg/ml |
| technique(s) | immunofluorescence: 1:50-1:200 immunohistochemistry: 1:50-1:200 western blot: 1:500-1:2000 |
| UniProt accession no.【UniProt登记号】 | P99999 |
| shipped in【运输】 | wet ice |
| storage temp.【储存温度】 | −20℃ |
| Gene Information | human ... CYCS(54205) |
基本信息
| General description【一般描述】 | This gene encodes a small heme protein that functions as a central component of the electron transport chain in mitochondria. The encoded protein associates with the inner membrane of the mitochondrion where it accepts electrons from cytochrome b and transfers them to the cytochrome oxidase complex. This protein is also involved in initiation of apoptosis. Mutations in this gene are associated with autosomal dominant nonsyndromic thrombocytopenia. Numerous processed pseudogenes of this gene are found throughout the human genome. |
| Immunogen【免疫原】 | Recombinant fusion protein containing a sequence corresponding to amino acids 1-105 of human Cytochrome c (NP_061820.1). |
| Physical form【外形】 | PBS with 0.02% sodium azide,50% glycerol,pH7.3. |
产品说明
| Storage and Stability【储存及稳定性】 | Store at -20℃. Avoid freeze / thaw cycles. |
安全信息
| Storage Class Code【储存分类代码】 | 12 - Non Combustible Liquids |